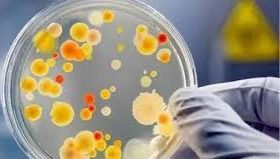
Methods for Purifying Contaminated Microbial Strains Under Different Conditions

Methods for Purifying Contaminated Microbial Strains Under Different Conditions
News 11 9 月, 2024
Microbial strains are prone to contamination by unwanted bacteria, yeast, or molds during isolation, preservation, and production processes. It is crucial to purify these contaminated strains to ensure their suitability for production. Depending on the type and degree of contamination, different purification methods must be employed. 1. Eliminating Bact…
Impact of Serum-Free Culture on HEK293 Cells: Growth and Metabolic Changes
News 10 9 月, 2024
Animal-derived serum, particularly fetal bovine serum (FBS), is commonly used as an additive in cell and tissue culture media, providing essential nutrients such as growth factors, adhesion factors, vitamins, transferrin, hormones, and trace elements that support cell growth in vitro. However, FBS presents challenges, including batch variability, risk of v…
HuanKai® Cell Culture Media and Reagents Product Catalog
News 6 9 月, 2024
Huankai® Cell Culture Media and Reagents Product Catalog Download PDF
The Role of HEPES Buffer in Cell Culture Media
News 6 9 月, 2024
When Should You Use HEPES in Cell Culture Media? HEPES (4-(2-hydroxyethyl)-1-piperazineethanesulfonic acid) is a commonly used zwitterionic buffer with a pKa of 7.3 at 37°C. In cell culture media, HEPES is often used alongside sodium bicarbonate to maintain a stable pH environment, essential for optimal cell growth and metabolism. If required, HEPES can…
HuanKai Group to Exhibit at ARABLAB LIVE 2024 in Dubai
News 30 8 月, 2024
We are excited to announce that HuanKai Group will be attending the ARABLAB LIVE 2024 exhibition, taking place from September 24-26, 2024, at the Dubai World Trade Centre. As a leading event for the global laboratory and scientific industry, ARABLAB LIVE is where innovation drives the future of laboratory technology. ARABLABLIVE.Invit…
Shigella Infections: Causes, Symptoms, and Effective Treatments
News 24 8 月, 2024
Shigella is responsible for causing acute gastrointestinal infections, clinically known as bacillary dysentery. This condition arises from Shigella infection, leading to purulent ulcerative inflammation of the colonic mucosa. The inflammation can cause symptoms such as fever, diarrhea, and abdominal pain, with severe cases resulting in mucus-filled, bloody…
Understanding Bacteriophages: Detection Methods and Applications
News 18 8 月, 2024
Bacteriophages, often referred to as phages, are viruses that specifically infect bacteria. They have distinctive viral morphology and structure and exhibit high specificity towards their bacterial hosts. This host specificity is useful for strain identification but can vary. Phages attach to specific receptor sites on the bacterial cell surface using thei…
Understanding Food Poisoning: Causes, Symptoms, and Prevention
News 15 8 月, 2024
What is Food Poisoning? Food poisoning, also known as foodborne illness, occurs when harmful bacteria, viruses, or toxins are ingested through contaminated food. Common sources of contamination include meat, shellfish, fish, dairy products, produce, and even certain liquids. Consuming contaminated food can lead to various health issues, which can be par…
Maintenance and Cleaning Methods for Common Laboratory Instruments
News 31 7 月, 2024
Laboratory instruments are essential partners in our work. Proper use and maintenance habits can make our experiments smoother and more efficient. So, how should these instruments be maintained? Let’s explore some key methods together. Electronic Balance Electronic balances are indispensable for weighing in experiments. While most lab personnel…
The Impact of pH on Cell Culture Media
News 31 7 月, 2024
Cell culture media are vital for providing the necessary nutrients and environment for cell growth and proliferation. The pH of the media is a crucial factor that can significantly affect cell health and experimental outcomes. While cell culture techniques are generally similar, the specific conditions required for different cell types can vary widely. Dev…
Common Additives in Cell Culture Media: An Overview
News 31 7 月, 2024
Cell Culture Additives Cell culture is an essential experimental method in biological research, providing the nutrients and environment necessary for cell growth and proliferation. Cell culture media are crucial in this process, serving as both the nutritional supply and living environment for cells. Typically, serum is added to the cell culture medi…
Key Factors Affecting Cell Culture: Cell Density
News 31 7 月, 2024
Cell Culture Insights Cell culture is a fundamental experimental technique in biological research. Successful cell culture is essential for advancing cell biology studies. Among the many factors influencing cell culture conditions, cell density stands out as a critical one. Understanding Cell Density Cell Density 1. What is Cell Density?…